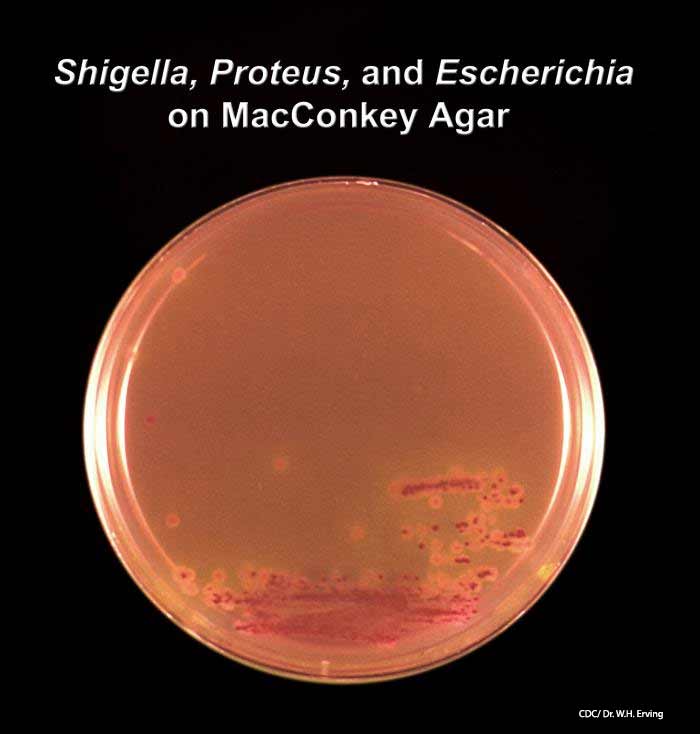

Foodsafety.gov
FoodSafety.gov is the gateway to food safety information provided by government agencies, including the Food and Drug Administration, Centers for Disease Control and Prevention, and the USDA’s Food Safety Inspection Service.
Food and Drug Administration (FDA)
The FDA provides information on recalls, outbreaks, pathogens, food defense (preventing intentional attacks against our food supply), and other topics. The FDA provides recall information on non-meat products. Generally, the FDA and CDC only get involved in a foodborne outbreak if there are two or more states involved or if there is a large outbreak in one state, and the local health department can’t figure out the source. The FDA’s role in outbreaks includes traceback investigations and inspections of implicated facilities.
Centers for Disease Control and Prevention (CDC)
There is a wealth of information on the CDC website, including the following:
- Foodborne Outbreak Online Database (FOOD Tool), which is what the name implies, a searchable database of past and present outbreaks;
- Be Food Safe, information on protecting yourself from food poisoning;
- Foodborne Illness Fact Sheets;
- Foodborne Diseases Active Surveillance Network (FoodNet), a database for reports of foodborne illness across the United States that tracks trends and is instrumental in finding multistate outbreaks;
- Specific pathogens, including Campylobacter, E. coli, Listeria, Salmonella, Shigella, and others.
The CDC labs test isolates from blood and urine samples, food samples, and environmental samples (swabs of equipment, counter tops, floors, etc.).
Food Safety Inspection Service (FSIS)
The FSIS, part of the U.S. Department of Agriculture, regulates the meat and poultry industries, inspects meat and poultry processing plants, and oversees recalls of potentially contaminated products. FSIS has a service called “Ask Karen” that provides information for consumers about preventing foodborne illness, safe food handling and storage, and safe preparation of meat, poultry, and egg products.
Morbidity and Mortality Weekly Report
This is a CDC publication that has in-depth articles and surveillance information. According to the CDC, “the MMWR series is the agency’s primary vehicle for scientific publication of timely, reliable, authoritative, accurate, objective, and useful public health information and recommendations.”
Fight BAC!
Fight BAC! is a privately and publicly funded organization whose goal is to educate consumers about food safety. The primary campaign exists to promote the four core practices of clean, separate, cook, and chill.